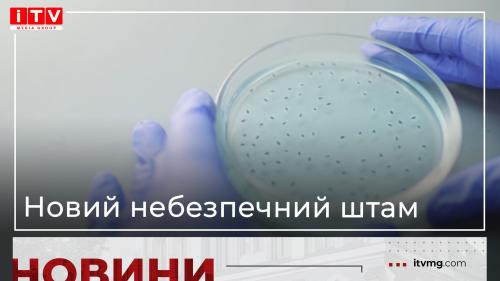

Всі новини за тегом "covid-19"

Коронавірус повертається: як стрімко зростає кількість хворих на Рівненщині (ВІДЕО)
05.08.2022 20:31

В Україні людям, які отримали бустерну дозу, даруватимуть знижку на поїздку в таксі
08.02.2022 16:20

У Рівному лікар вигнав з кабінету дитину із зламаною рукою, через відсутність маски
04.02.2022 10:49

"Доступні ліки" для хронічних хвороб: на нові препарати виділили майже два мільярди
03.02.2022 14:11

МОЗ: Уперше з початку пандемії було зроблено понад 100 тисяч ПЛР-досліджень за добу
03.02.2022 12:10

Депутати Вараської міської ради виділили майже 2 мільйони для придбання тест-систем
19.11.2021 11:08

Пів тисячі - у важкому стані, 9 жителів Рівненщини померли за добу від коронавірусу
12.04.2021 10:17

Більше 3 тисяч випадків захворювання на коронавірус зафіксували в Україні за добу
11.09.2020 09:37

Місцеві бюджети Рівненщини від плати за ліцензії отримали понад 6 мільйонів гривень
27.05.2020 11:09

COVID-19 на Рівненщині: 32 нових випадки, серед них 4 дітей, ще одна людина померла
22.05.2020 19:19

Карантин на Рівненщині: навіщо носити документи і маску та за що можуть оштрафувати
06.04.2020 11:42